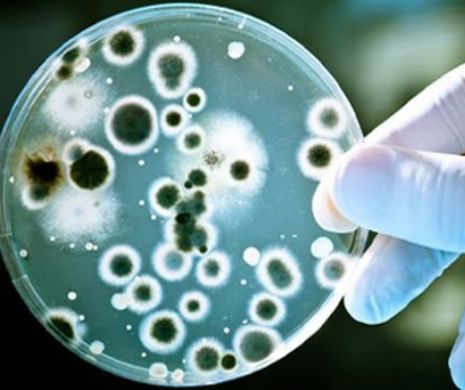

ALERTĂ. Spitalele au fost pur și simplu luate cu asalt. Bacterii EXTREM de periculoase în apa potabilă
- Lucian Ionescu
- 10 septembrie 2018, 18:35
O situație extrem de periculoasă se întâmplă în orașul italian Brescia și împrejurimile acestuia. În fiecare zi la spitalele din regiune se prezintă zeci de persoane cu simptome de pneumonie. Deja două persoane au decedat din cauza acestei boli ivită din senin. Autoritățile au deschis o anchetă pentru a se constata cauza acestei adevărate epidemii
Cazurile s-au concentrat în 6 localități la sud de Brescia. 150 de îmbolnăviri în doar câteva zile. Și acum, din ce în ce mai multe, potrivit stiri.tvr.ro
Majoritatea persoanelor afectate au peste 60 de ani. Cele care erau luate deja în evidență cu probleme de sănătate, fac forme mai grave ale bolii.
Se caută un vinovat. Și primul răspuns al autorităților sanitare a fost: Atenție! Verificăm eventuala prezență a unei bacterii în apa potabilă!
Dacă va fi confirmată contaminarea, următoarea întrebare va fi: cum a ajuns bacteria acolo?
Până la obținerea rezultatelor din probele de apă prelevate, localnicii sunt sfătuiți să își ia măsuri de precauție.
Filtrele robinetelor și furtunurilor de duș trebuie dezinfectate, apa lăsată să curgă înainte de utilizare, mai ales după o absență prelungită de acasă.
Persoanele cu o sănătate fragilă trebuie să consulte medicul imediat după apariția febrei sau a dificultăților respiratorii.